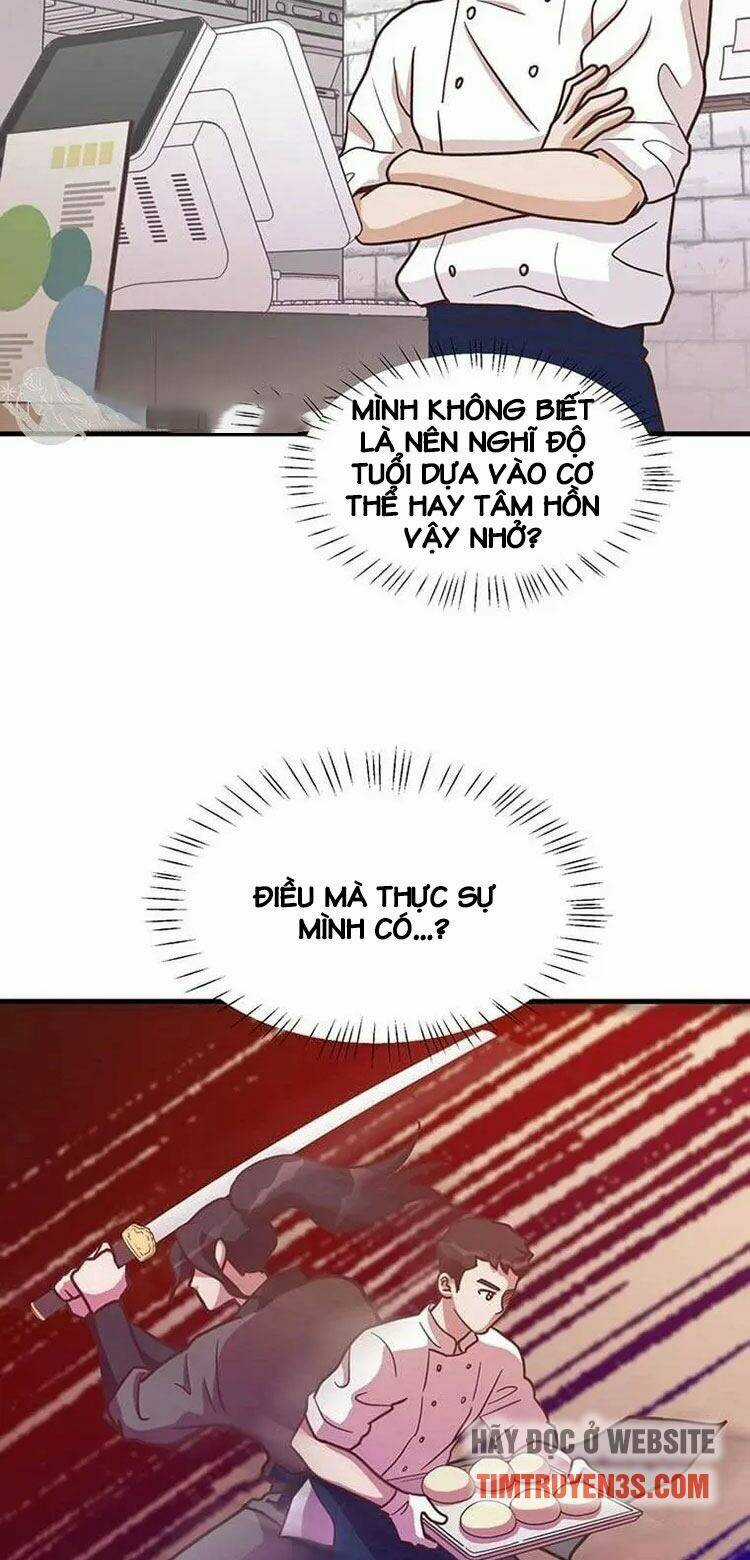
Tiệm Bánh Của Thiên Quỷ Chapter 9 trang 56

Cập nhật lúc 10:57:47 15 tháng 11, 2023
MangaTruyenVietThế giới truyện tranh đa thể loại, từ hành động, lãng mạn, hài hước, fantasy, chuyển sinh, cổ đại, đời thường, bí ẩn đến học đường. Giao diện thân thiện cùng công cụ tìm kiếm nhanh chóng, chính xác, giúp bạn dễ dàng khám phá truyện mới hoặc theo dõi series yêu thích.
Chúng tôi cập nhật liên tục các chương mới nhất và những bộ manga hot, đảm bảo bạn không bỏ lỡ bất kỳ nội dung hấp dẫn nào. Đăng ký ngay để nhận thông báo và tham gia cộng đồng độc giả sôi động của MangaTruyenViet. Chúc bạn có những phút giây thư giãn và trải nghiệm tuyệt vời trong thế giới truyện tranh!
© MangaTruyenViet